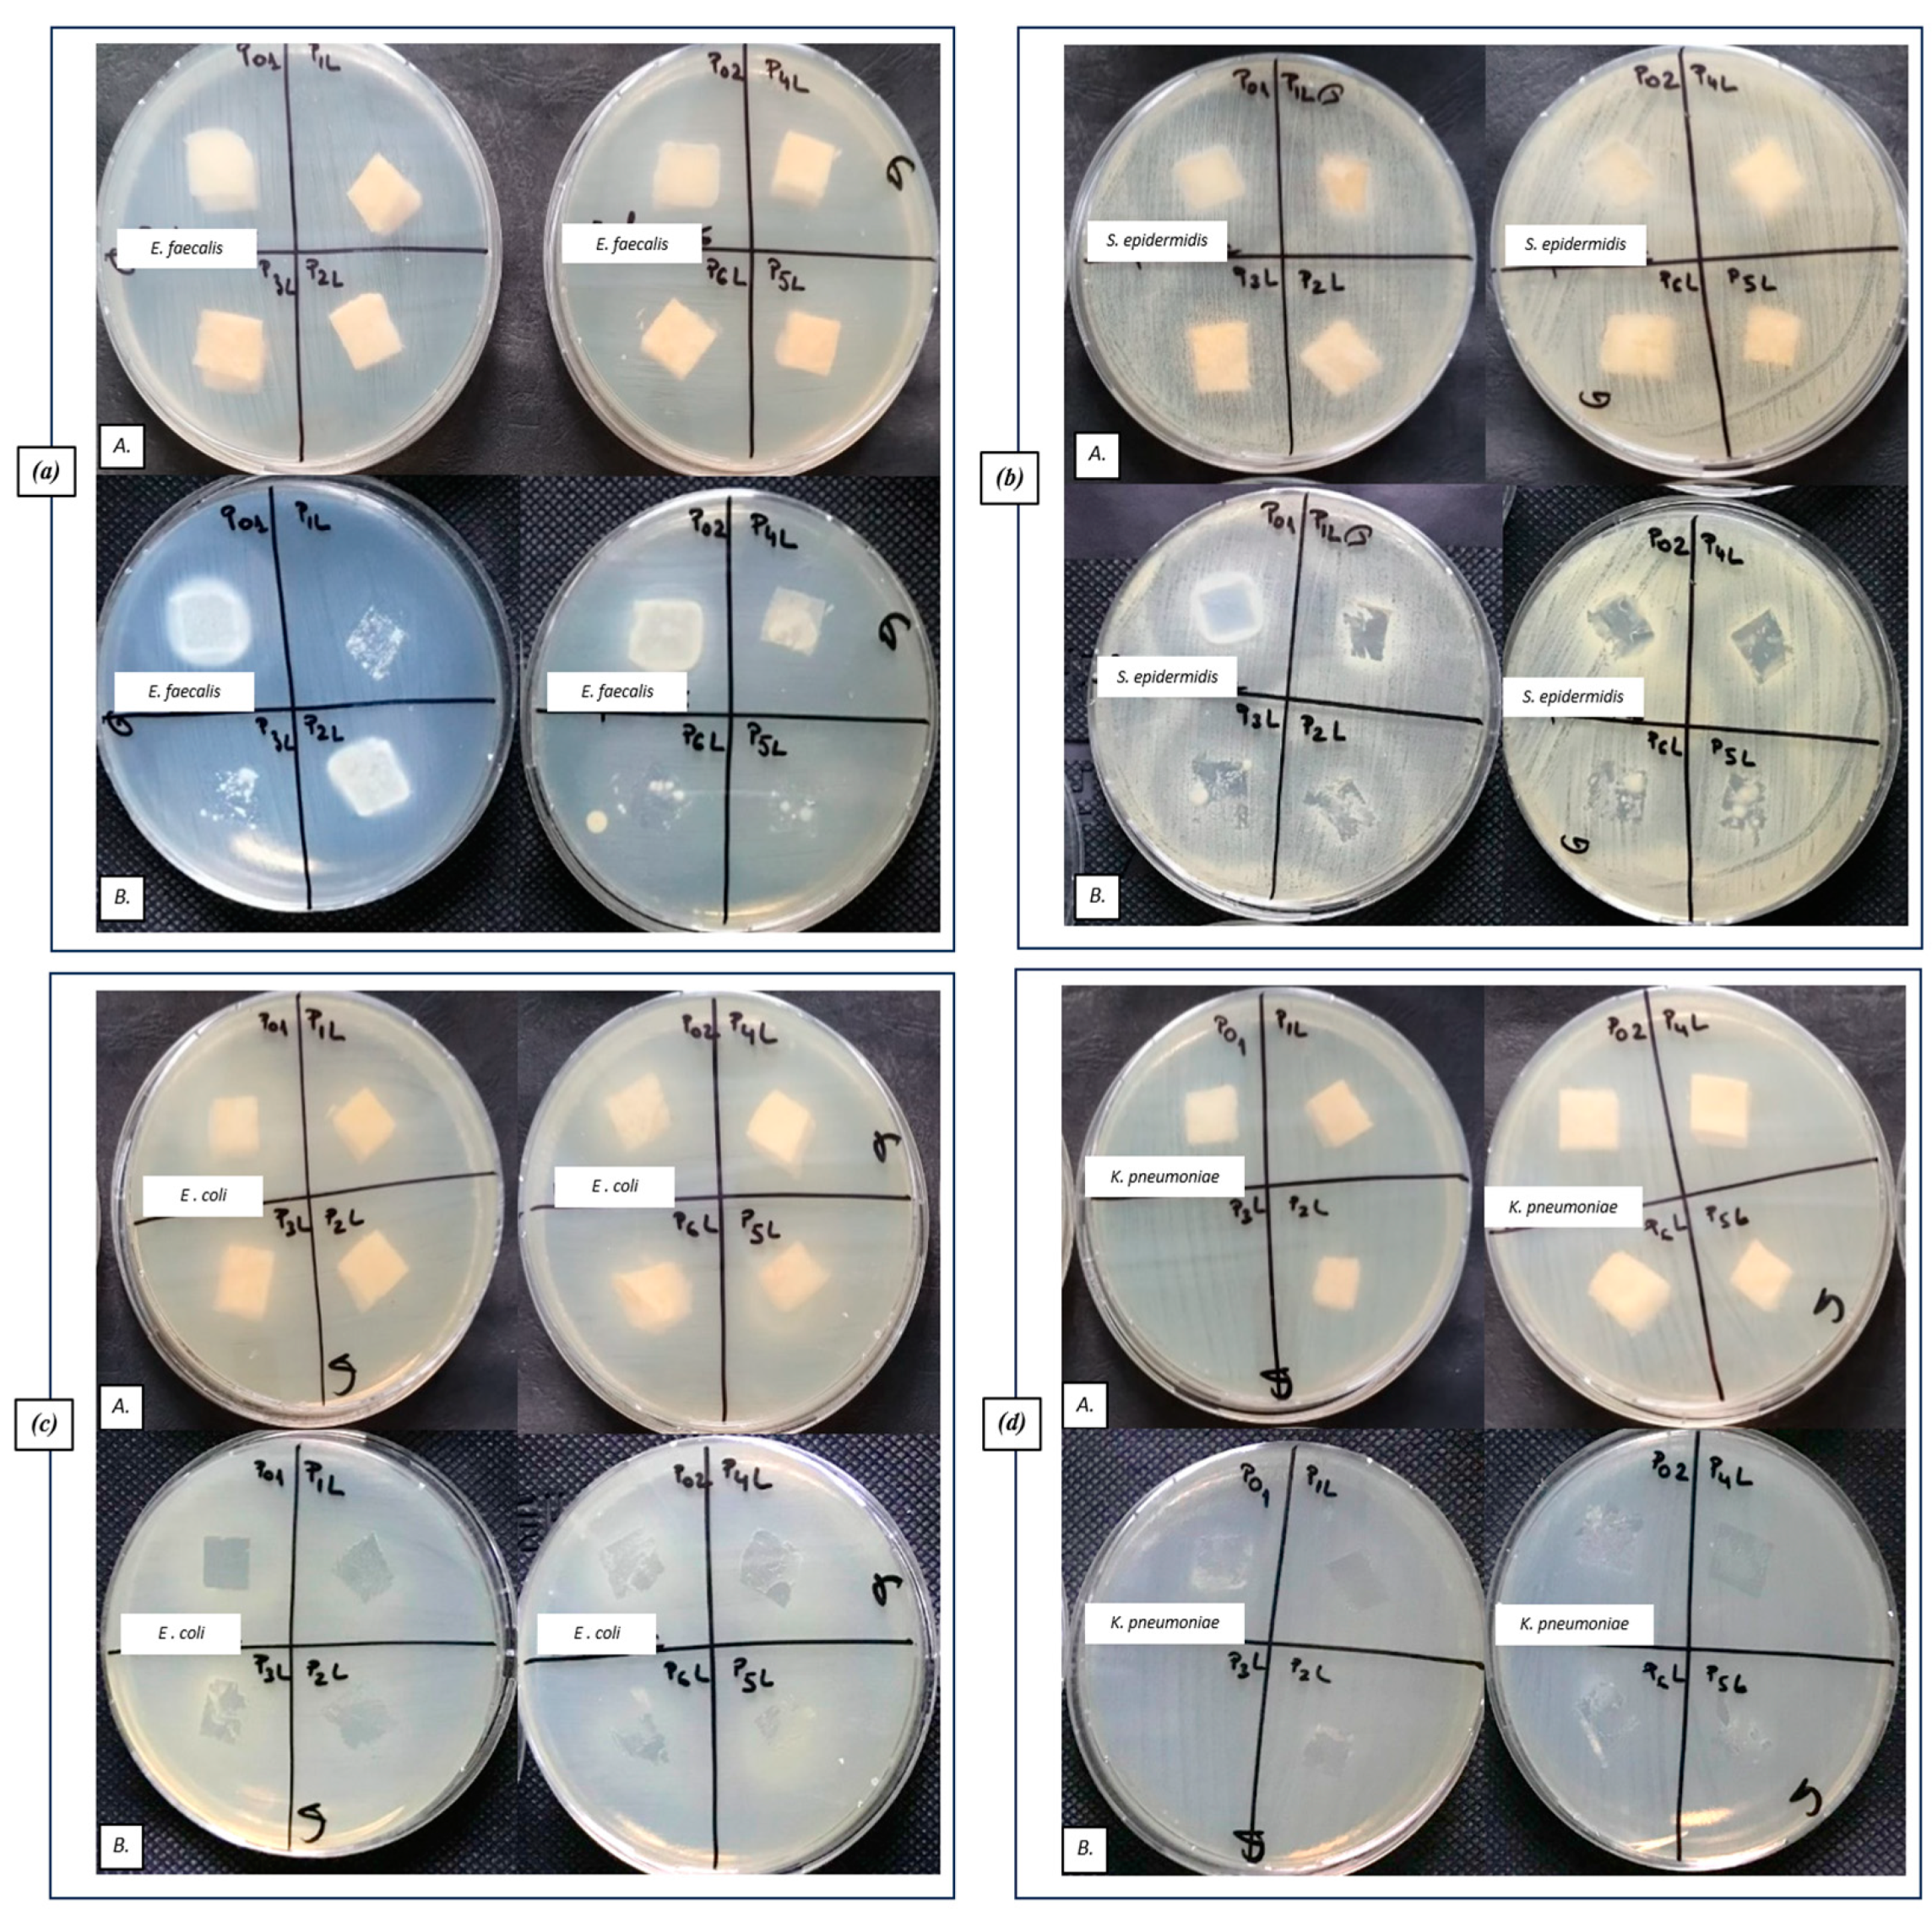

Influence of Lavender Essential Oil on the Physical and Antibacterial Properties of Chitosan Sponge for Hemostatic Applications
Abstract
1. Introduction
2. Results and Discussion
2.1. ATR-FTIR
2.2. SEM
2.3. Swelling Ratio and Degradation Rate in PBS Solution
- -
- Stage I (0–2 h): PBS penetrates the pores of the material, and the value of the mass of the samples registers a dynamic increase;
- -
- Stage II (2–4 h): the phenomenon of absorption of PBS in the mass of the material and swelling takes place, during which the dimensions of the samples and, implicitly, the mass increase until liquid saturation occurs;
- -
- Stage III (4–8 h): the mass of the samples stabilizes and keeps an approximately constant value.
2.4. UV–Vis and Fluorescence (PL) Spectroscopy
2.5. Complex Thermal Analysis: TG-DSC-FTIR
2.6. Antibacterial Analysis
2.6.1. Qualitative Screening for Evaluation of the Antibacterial Efficiency of Lavender Essential Oil
2.6.2. Qualitative Results Regarding the Antibacterial Efficiency of Tested Samples
2.6.3. Quantitative Evaluation of the Antibacterial Efficiency of Functionalized Samples
3. Materials and Methods
3.1. Materials
3.1.1. Raw Materials
3.1.2. Preparation of the Chitosan Sponges
3.2. Characterization Methods
3.2.1. FTIR Spectroscopy
3.2.2. UV–Vis Spectroscopy
3.2.3. Fluorescence (PL) Spectroscopy
3.2.4. SEM
3.3. Evaluation of the Samples Degradation in PBS
3.3.1. Swelling Properties
3.3.2. Mass Loss
3.4. Thermal Analisys
3.5. Antibacterial Analysis
3.5.1. Qualitative Method for Evaluation of the Antibacterial Efficiency of Lavender Essential Oil
3.5.2. Qualitative Method for Evaluation of the Antibacterial Efficiency of Tested Samples
3.5.3. Quantitative Method for Evaluating the Antibacterial Efficiency of Functionalized Sponge Samples by Determining CFU/mL Values
4. Conclusions
Supplementary Materials
Author Contributions
Funding
Institutional Review Board Statement
Informed Consent Statement
Data Availability Statement
Conflicts of Interest
References
- Moore, E.E.; Moore, H.B.; Kornblith, L.Z.; Neal, M.D.; Hoffman, M.; Mutch, N.J.; Schöchl, H.; Hunt, B.J.; Sauaia, A. Trauma—Induced Coagulopathy. Nat. Rev. Dis. Prim. 2021, 7, 30. [Google Scholar] [CrossRef]
- Dobson, G.P.; Morris, J.L.; Letson, H.L. Why are bleeding trauma patients still dying? Towards a systems hypothesis of trauma. Front. Physiol. 2022, 13, 990903. [Google Scholar] [CrossRef] [PubMed]
- Aditianingsih, D.; George, Y.W. Guiding principles of fluid and volume therapy. Best. Pract. Res. Clin. Anaesthesiol. 2014, 28, 249–260. [Google Scholar] [CrossRef]
- Gianola, S.; Castellini, G.; Biffi, A.; Porcu, G.; Napoletano, A.; Coclite, D.; D’Angelo, D.; Fauci, A.J.; Iacorossi, L.; Latina, R.; et al. Accuracy of risk tools to predict critical bleeding in major trauma: A systematic review with meta-analysis. J. Trauma Inj. Infect. Crit. Care 2022, 92, 1086–1096. [Google Scholar] [CrossRef] [PubMed]
- Aird, W.C. Spatial and temporal dynamics of the endothelium. J. Thromb. Haemost. 2005, 3, 1392–1406. [Google Scholar] [CrossRef] [PubMed]
- Malik, A.; Rehman, F.U.; Shah, K.U.; Naz, S.S.; Qaisar, S. Hemostatic strategies for uncontrolled bleeding: A comprehensive update. J. Biomed. Mater. Res. Part B Appl. Biomater. 2021, 109, 1465–1477. [Google Scholar] [CrossRef]
- Iosifescu, A.G.; Moldovan, H.; Iliescu, V.A. Aortic prosthesis-patient mismatch strongly affects early results of double valve replacement. J. Heart Valve Dis. 2014, 23, 149–157. [Google Scholar] [PubMed]
- Zhong, Y.; Hu, H.; Min, N.; Wei, Y.; Li, X.; Li, X. Application and outlook of topical hemostatic materials: A narrative review. Ann. Transl. Med. 2021, 9, 577. [Google Scholar] [CrossRef]
- Mecwan, M.; Li, J.; Falcone, N.; Ermis, M.; Torres, E.; Morales, R.; Hassani, A.; Haghniaz, R.; Mandal, K.; Sharma, S.; et al. Recent Advances in Biopolymer-Based Hemostatic Materials. Regen. Biomater. 2022, 9, rbac063. [Google Scholar] [CrossRef]
- Robu, M.; Marian, D.R.; Margarint, I.; Radulescu, B.; Știru, O.; Iosifescu, A.; Voica, C.; Cacoveanu, M.; Ciomag Ianula, R.; Gașpar, B.S.; et al. Association between Bilateral Selective Antegrade Cerebral Perfusion and Postoperative Ischemic Stroke in Patients with Emergency Surgery for Acute Type a Aortic Dissection-Single Centre Experience. Medicina 2023, 59, 1365. [Google Scholar] [CrossRef]
- Gheorghiță, D.; Moldovan, H.; Robu, A.; Bița, A.-I.; Grosu, E.; Antoniac, A.; Corneschi, I.; Antoniac, I.; Bodog, A.D.; Băcilă, C.I. Chitosan-Based Biomaterials for Hemostatic Applications: A Review of Recent Advances. Int. J. Mol. Sci. 2023, 24, 10540. [Google Scholar] [CrossRef]
- Mohamed, E.; Fitzgerald, A.; Tsuzuki, T. The role of nanoscale structures in the development of topical hemostatic agents. Mater. Today Nano 2021, 16, 100137. [Google Scholar] [CrossRef]
- Renkens, K.L.; Payner, T.D.; Leipzig, T.J.; Feuer, H.; Morone, M.A.; Koers, J.M.; Lawson, K.J.; Lentz, R.; Shuey, H.; Conaway, G.L.; et al. A Multicenter, Prospective, Randomized Trial Evaluating a New Hemostatic Agent for Spinal Surgery. Spine 2001, 26, 1645–1650. [Google Scholar] [CrossRef] [PubMed]
- Du, J.; Wang, J.; Xu, T.; Yao, H.; Yu, L.; Huang, D. Hemostasis Strategies and Recent Advances in Nanomaterials for Hemostasis. Molecules 2023, 28, 5264. [Google Scholar] [CrossRef] [PubMed]
- Sierra, C.; Moreno, M.; García-Ruiz, J.C. The physiology of hemostasis. Blood Coagul. Fibrinolysis 2022, 33 (Suppl. S1), S1–S2. [Google Scholar] [CrossRef]
- Kauvar, D.S.; Lefering, R.; Wade, C.E. Impact of hemorrhage on trauma outcome: An overview of epidemiology, clinical presentations, and therapeutic considerations. J. Trauma. 2006, 60, S3–S11. [Google Scholar] [CrossRef]
- Bennett, B.L.; Littlejohn, L. Review of new topical hemostatic dressings for combat casualty care. Mil. Med. 2014, 179, 497–514. [Google Scholar] [CrossRef]
- Guo, Y.; Wang, M.; Liu, Q.; Liu, G.; Wang, S.; Li, J. Recent advances in the medical applications of hemostatic materials. Theranostics 2023, 13, 161–196. [Google Scholar] [CrossRef]
- Seyednejad, H.; Imani, M.; Jamieson, T.; Seifalian, A.M. Topical haemostatic agents. Br. J. Surg. 2008, 95, 1197–1225. [Google Scholar] [CrossRef]
- Levi, M.; Keller, T.T.; Gorp, E.; Cate, H. Infection and inflammation and the coagulation system. Cardiovasc. Res. 2003, 60, 26–39. [Google Scholar] [CrossRef]
- Rusu, E.; Sarbu, I.; Mitache, M.; Moldovan, H.; Biris, C.I.; Vassu, T.; Pelinescu, D. Ultrastructural Changes of Candida albicans Species Induced by the Presence of Sodium Diclofenac. Rev. Chim. 2017, 68, 2566–2569. [Google Scholar] [CrossRef]
- Vivcharenko, V.; Trzaskowska, M.; Przekora, A. Wound Dressing Modifications for Accelerated Healing of Infected Wounds. Int. J. Mol. Sci. 2023, 24, 7193. [Google Scholar] [CrossRef] [PubMed]
- Cañedo-Dorantes, L.; Cañedo-Ayala, M. Skin Acute Wound Healing: A Comprehensive Review. Int. J. Inflam. 2019, 2019, 3706315. [Google Scholar] [CrossRef] [PubMed]
- Bal-Ozturk, A.; Karal-Yilmaz, O.; Akguner, Z.P.; Aksu, S.; Tas, A.; Olmez, H. Sponge-like Chitosan-Based Nanostructured Antibacterial Material as a Topical Hemostat. J. Appl. Polym. Sci. 2019, 136, 47522. [Google Scholar] [CrossRef]
- Rodrigues, M.; Kosaric, N.; Bonham, C.A.; Gurtner, G.C. Wound Healing: A Cellular Perspective. Physiol. Rev. 2019, 99, 665–706. [Google Scholar] [CrossRef]
- Thurman, P. Hemostatic Strategies in Trauma. AACN Adv. Crit. Care 2021, 32, 51–63. [Google Scholar] [CrossRef]
- Wang, C.-H.; Cherng, J.-H.; Liu, C.-C.; Fang, T.-J.; Hong, Z.-J.; Chang, S.-J.; Fan, G.-Y.; Hsu, S.-D. Procoagulant and Antimicrobial Effects of Chitosan in Wound Healing. Int. J. Mol. Sci. 2021, 22, 7067. [Google Scholar] [CrossRef]
- Flanagan, M. The physiology of wound healing. J. Wound Care 2000, 9, 299–300. [Google Scholar] [CrossRef]
- Simpson, A.; Shukla, A.; Brown, A.C. Biomaterials for Hemostasis. Annu. Rev. Biomed. Eng. 2022, 24, 111–135. [Google Scholar] [CrossRef]
- Moldovan, H.; Antoniac, I.; Gheorghiță, D.; Safta, M.S.; Preda, S.; Broască, M.; Badilă, E.; Fronea, O.; Scafa-Udrişte, A.; Cacoveanu, M.; et al. Biomaterials as Haemostatic Agents in Cardiovascular Surgery: Review of Current Situation and Future Trends. Polymers 2022, 14, 1189. [Google Scholar] [CrossRef]
- Ghimire, S.; Sarkar, P.; Rigby, K.; Maan, A.; Mukherjee, S.; Crawford, K.E.; Mukhopadhyay, K. Polymeric Materials for Hemostatic Wound Healing. Pharmaceutics 2021, 13, 2127. [Google Scholar] [CrossRef] [PubMed]
- Tiplea, R.E.; Lemnaru, G.M.; Trusca, R.D.; Holban, A.; Kaya, M.G.A.; Dragu, L.D.; Ficai, D.; Ficai, A.; Bleotu, C. Antimicrobial Films Based on Chitosan, Collagen, and Zno for Skin Tissue Regeneration. Biointerface Res. Appl. Chem. 2021, 11, 11985–11995. [Google Scholar]
- Tompeck, A.J.; Gajdhar, A.U.R.; Dowling, M.; Johnson, S.B.; Barie, P.S.; Winchell, R.J.; King, D.; Scalea, T.M.; Britt, L.; Narayan, M. A comprehensive review of topical hemostatic agents: The good, the bad, and the novel. J. Trauma Inj. Infect. Crit. Care 2020, 88, e1–e21. [Google Scholar] [CrossRef] [PubMed]
- Antoniac, I. (Ed.) Biologically Responsive Biomaterials for Tissue Engineering; Springer: New York, NY, USA, 2013; Volume 1, ISBN 978-1-4614-4327-8. [Google Scholar]
- Behrens, A.M.; Sikorski, M.J.; Kofinas, P. Hemostatic strategies for traumatic and surgical bleeding. J. Biomed. Mater. Res. Part A 2014, 102, 4182–4194. [Google Scholar] [CrossRef]
- Khoshmohabat, H.; Paydar, S.; Kazemi, H.M.; Dalfardi, B. Overview of Agents Used for Emergency Hemostasis. Trauma Mon. 2016, 21, e26023. [Google Scholar] [CrossRef] [PubMed]
- Chiara, O.; Cimbanassi, S.; Bellanova, G.; Chiarugi, M.; Mingoli, A.; Olivero, G.; Ribaldi, S.; Tugnoli, G.; Basilicò, S.; Bindi, F.; et al. A systematic review on the use of topical hemostats in trauma and emergency surgery. BMC Surg. 2018, 18, 1–20. [Google Scholar] [CrossRef]
- Moharir, K.S.; Kurakula, M.; Kale, V.; Kenawy, E.-R.; Murtuja, S.; Ahsan, M.N.; Hasnain, M.S.; Nayak, A.K. Chapter 4—Biomedical Applications of Electrospun Chitosan Nanofibers, Chitosan in Biomedical Applications; Academic Press: Cambridge, MA, USA, 2022; pp. 75–110. [Google Scholar]
- Huang, L.; Liu, G.L.; Kaye, A.D.; Liu, H. Advances in Topical Hemostatic Agent Therapies: A Comprehensive Update. Adv. Ther. 2020, 37, 4132–4148. [Google Scholar] [CrossRef]
- Moldovan, H.; Gheorghita, D.; Antoniac, I.; Gheorghe, D.; Fiori, F.; Mohan, A.; Raftu, G.; Ionel, C.; Costache, V. Bioadhesives Used in Cardiovascular Surgery. Rev. Chim. 2018, 69, 2799–2803. [Google Scholar] [CrossRef]
- Benesch, J.; Tengvall, P. Blood protein adsorption onto chitosan. Biomaterials 2002, 23, 2561–2568. [Google Scholar] [CrossRef]
- Zhou, X.; Zhang, X.; Zhou, J.; Li, L. An investigation of chitosan and its derivatives on red blood cell agglutination. RSC Adv. 2017, 7, 12247–12254. [Google Scholar] [CrossRef]
- Pogorielov, M.V.; Sikora, V.Z. Chitosan as a Hemostatic Agent: Current State. Eur. J. Med. Ser. B 2015, 2, 24–33. [Google Scholar] [CrossRef]
- Wang, Y.W.; Liu, C.C.; Cherng, J.H.; Lin, C.S.; Chang, S.J.; Hong, Z.J.; Liu, C.C.; Chiu, Y.K.; Hsu, S.D.; Chang, A.H. Biological Effects of Chitosan-Based Dressing on Hemostasis Mechanism. Polymers 2019, 11, 1906. [Google Scholar] [CrossRef] [PubMed]
- Kurakula, M.; Gorityala, S.; Patel, D.B.; Basim, P.; Patel, B.; Kumar Jha, S. Trends of Chitosan Based Delivery Systems in Neuroregeneration and Functional Recovery in Spinal Cord Injuries. Polysaccharides 2021, 2, 519–537. [Google Scholar] [CrossRef]
- Fan, P.; Zeng, Y.; Zaldivar-Silva, D.; Agüero, L.; Wang, S. Chitosan-Based Hemostatic Hydrogels: The Concept, Mechanism, Application, and Prospects. Molecules 2023, 28, 1473. [Google Scholar] [CrossRef]
- Ouyang, Y.; Zhao, Y.; Zheng, X.; Zhang, Y.; Zhao, J.; Wang, S.; Gu, Y. Rapidly degrading and mussel-inspired multifunctional carboxymethyl chitosan/montmorillonite hydrogel for wound hemostasis. Int. J. Biol. Macromol. 2023, 242, 124960. [Google Scholar] [CrossRef]
- Radhakrishna, S.; Shukla, V.; Shetty, S.K. Is Chitosan Dental Dressing Better Than Cotton Gauze in Achieving Hemostasis in Patients on Antithrombotics? J. Oral Maxillofac. Surg. 2023, 81, 224–231. [Google Scholar] [CrossRef]
- Petrov, L.; Stoilova, O.; Pramatarov, G.; Kanzova, H.; Tsvetanova, E.; Andreeva, M.; Georgieva, A.; Atanasova, D.; Philipov, S.; Alexandrova, A. Effect of Chitosan-Diosgenin Combination on Wound Healing. Int. J. Mol. Sci. 2023, 24, 5049. [Google Scholar] [CrossRef] [PubMed]
- Xiang, F.; Bai, J.; Tan, X.; Chen, T.; Yang, W.; He, F. Antimicrobial activities and mechanism of the essential oil from Artemisia argyi Levl. et Van. var. argyi cv. Qiai. Ind. Crop. Prod. 2018, 125, 582–587. [Google Scholar] [CrossRef]
- Miranda, C.A.S.F.D.; Cardoso, M.D.G.; Marcussi, S.; Teixeira, M.L. Clotting and fibrinogenolysis inhibition by essential oils from species of the Asteraceae family. Braz. Arch. Biol. Techn. 2016, 59, 1678–4324. [Google Scholar] [CrossRef][Green Version]
- Sui, J.; Wang, B.; Yu, Z. A novel hemostatic model with triple protective functions. Med. Hypotheses 2009, 72, 186–187. [Google Scholar] [CrossRef]
- Zhang, Y.; Wang, J.; Li, Y.; Wang, Y.; Jiang, P.; Liu, X. Improvement of application properties of chitosan-based food packaging films by lavender essential oil. Trans. Chin. Soc. Agric. Eng. 2014, 30, 286–292. [Google Scholar]
- Zhang, Z.H.; Qin, Y.Y.; Fan, J.; Zhao, T.R.; Cheng, C.S. Physical Properties and Antibacterial Activity of a Chitosan Film Incorporated with Lavender Essential Oil. Adv. Mater. Res. 2013, 706–708, 197–200. [Google Scholar] [CrossRef]
- Lis-Balchin, M.; Hart, S. Studies on the mode of action of the essential oil of Lavender (Lavandula angustifolia P. Miller). Phytother. Res. 1999, 13, 540–542. [Google Scholar] [CrossRef]
- Samuelson, R.; Lobl, M.; Higgins, S.; Clarey, D.; Wysong, A. The Effects of Lavender Essential Oil on Wound Healing: A Review of the Current Evidence. J. Altern. Complement. Med. 2020, 26, 680–690. [Google Scholar] [CrossRef] [PubMed]
- Jamróz, E.; Juszczak, L.; Kucharek, M. Investigation of the physical properties, antioxidant and antimicrobial activity of ternary potato starch-furcellaran-gelatin films incorporated with lavender essential oil. Int. J. Biol. Macromol. 2018, 114, 1094–1101. [Google Scholar] [CrossRef]
- Mesic, A.; Mahmutović-Dizdarević, I.; Tahirović, E.; Durmišević, I.; Eminovic, I.; Jerković-Mujkić, A.; Bešta-Gajević, R. Evaluation of toxicological and antimicrobial activity of lavender and immortelle essential oils. Drug Chem. Toxicol. 2021, 44, 190–197. [Google Scholar] [CrossRef]
- Gheorghita, D.; Grosu, E.; Robu, A.; Ditu, L.M.; Deleanu, I.M.; Gradisteanu Pircalabioru Pircalabioru, G.; Raiciu, A.-D.; Bita, A.-I.; Antoniac, A.; Antoniac, V.I. Essential Oils as Antimicrobial Active Substances in Wound Dressings. Materials 2022, 15, 6923. [Google Scholar] [CrossRef]
- Ali-Shtayeh, M.S.; Abu-Zaitoun, S.Y.; Dudai, N.; Jamous, R.M. Downy Lavender Oil: A Promising Source of Antimicrobial, Antiobesity, and Anti-Alzheimer’s Disease Agents. Evidence-Based Complement. Altern. Med. 2020, 2020, 5679408. [Google Scholar] [CrossRef]
- Kajjari, S.; Joshi, R.S.; Hugar, S.M.; Gokhale, N.; Meharwade, P.; Uppin, C. The Effects of Lavender Essential Oil and its Clinical Implications in Dentistry: A Review. Int. J. Clin. Pediatr. Dent. 2022, 15, 385–388. [Google Scholar]
- Predoi, D.; Iconaru, S.L.; Buton, N.; Badea, M.L.; Marutescu, L. Antimicrobial Activity of New Materials Based on Lavender and Basil Essential Oils and Hydroxyapatite. Nanomaterials 2018, 8, 291. [Google Scholar] [CrossRef]
- de Rapper, S.; Viljoen, A.; Vuuren, S. The in vitro antimicrobial effects of Lavandula angustifolia essential oil in combination with conventional antimicrobial agents. Evid. Based Complement. Altern. Med. 2016, 2016, 2752739. [Google Scholar] [CrossRef]
- Syafiuddin, A.; Salmiati, S.; Salim, M.R.; Beng, A.; Kueh, H.; Hadibarata, T.; Nur, H. A review of silver nanoparticles: Research trends, global consumption, synthesis, properties, and future challenges. J. Chin. Chem. Soc. 2017, 64, 732–756. [Google Scholar] [CrossRef]
- Niska, K.; Zielinska, E.; Radomski, M.W.; Inkielewicz-Stepniak, I. Metal nanoparticles in dermatology and cosmetology: Interactions with human skin cells. Chem. Biol. Interact. 2018, 295, 38–51. [Google Scholar] [CrossRef] [PubMed]
- Kim, M.H. Nanoparticle-based therapies for wound biofilm infection: Opportunities and challenges. IEEE Trans. Nanobiosci. 2016, 15, 294–304. [Google Scholar] [CrossRef] [PubMed]
- Robu, A.; Antoniac, A.; Ciocoiu, R.; Grosu, E.; Rau, J.V.; Fosca, M.; Krasnyuk, I.I., Jr.; Pircalabioru, G.G.; Manescu Paltanea, V.; Antoniac, I.; et al. Effect of the Antimicrobial Agents Peppermint Essential Oil and Silver Nanoparticles on Bone Cement Properties. Biomimetics 2022, 7, 137. [Google Scholar] [CrossRef] [PubMed]
- Râpă, M.; Stefan, L.M.; Zaharescu, T.; Seciu, A.-M.; Țurcanu, A.A.; Matei, E.; Predescu, A.M.; Antoniac, I.; Predescu, C. Development of Bionanocomposites Based on PLA, Collagen and AgNPs and Characterization of Their Stability and In Vitro Biocompatibility. Appl. Sci. 2020, 10, 2265. [Google Scholar] [CrossRef]
- Yang, C.M.; Lee, J.; Lee, S.Y.; Lee, H.; Chathuranga, K.; Lee, J.; Park, W. Silk Fibroin/Tannin/ZnO Nanocomposite Hydrogel with Hemostatic Activities. Gels 2022, 8, 650. [Google Scholar] [CrossRef]
- Rath, G.; Hussain, T.; Chauhan, G.; Garg, T.; Goyal, A.K. Collagen nanofiber containing silver nanoparticles for improved wound-healing applications. J. Drug Target 2016, 24, 520–529. [Google Scholar] [CrossRef]
- Rodríguez-Acosta, H.; Tapia-Rivera, J.M.; Guerrero-Guzmán, A.; Hernández-Elizarraráz, E.; Hernández-Díaz, J.A.; Garza-García, J.J.O.; Pérez-Ramírez, P.E.; Velasco-Ramírez, S.F.; Ramírez-Anguiano, A.C.; Velázquez-Juárez, G.; et al. Chronic wound healing by controlled release of chitosan hydrogels loaded with silver nanoparticles and calendula extract. J. Tissue Viability 2022, 31, 173–179. [Google Scholar] [CrossRef]
- Milić, M.; Cvetić, Ž.; Bendelja, K.; Vuković, B.; Galić, E.; Ćurlin, M.; Dobrošević, B.; Jurak Begonja, A.; Vinković Vrček, I. Response of platelets to silver nanoparticles designed with different surface functionalization. J. Inorg. Biochem. 2021, 224, 111565. [Google Scholar] [CrossRef]
- Abd El-Kader, M.F.H.; Elabbasy, M.T.; Ahmed, M.K.; Menazea, A.A. Structural, morphological features, and antibacterial behavior of PVA/PVP polymeric blends doped with silver nanoparticles via pulsed laser ablation. J. Mater. Res. Technol. 2021, 13, 291–300. [Google Scholar] [CrossRef]
- Bardania, H.; Mahmoudi, R.; Bagheri, H.; Salehpour, Z.; Fouani, M.H.; Darabian, B.; Khoramrooz, S.S.; Mousavizadeh, A.; Kowsari, M.; Moosavifard, S.E.; et al. Facile preparation of a novel biogenic silver-loaded Nanofilm with intrinsic anti-bacterial and oxidant scavenging activities for wound healing. Sci. Rep. 2020, 10, 6129. [Google Scholar] [CrossRef] [PubMed]
- Franková, J.; Pivodová, V.; Vágnerová, H.; Juráňová, J.; Ulrichová, J. Effects of silver nanoparticles on primary cell cultures of fibroblasts and keratinocytes in a wound-healing model. J. Appl. Biomater. Funct. Mater. 2016, 14, e137–e142. [Google Scholar] [CrossRef] [PubMed]
- Milić, M.; Vuković, B.; Barbir, R.; Pem, B.; Milić, M.; Šerić, V.; Frőhlich, E.; Vinković Vrček, I. Effect of Differently Coated Silver Nanoparticles on Hemostasis. Platelets 2021, 32, 651–661. [Google Scholar] [CrossRef] [PubMed]
- Zhou, P.; Xia, Z.; Qi, C.; He, M.; Yu, T.; Shi, L. Construction of Chitosan/Ag Nanocomposite Sponges and Their Properties. Int. J. Biol. Macromol. 2021, 192, 272–277. [Google Scholar] [CrossRef] [PubMed]
- Nam, G.; Rangasamy, S.; Purushothaman, B.; Song, J.M. The application of bactericidal silver nanoparticles in wound treatment. Nanomater. Nanotechnol. 2015, 5, 23. [Google Scholar] [CrossRef]
- Liu, X.; Lee, P.Y.; Ho, C.M.; Lui, V.C.; Chen, Y.; Che, C.M.; Tam, P.K.; Wong, K.K. Silver nanoparticles mediate differential responses in keratinocytes and fibroblasts during skin wound healing. Chem. Med. Chem. 2010, 5, 468–475. [Google Scholar] [CrossRef]
- Adibhesami, M.; Ahmadi, M.; Farshid, A.A.; Sarrafzadeh-Rezaei, F.; Dalir-Naghadeh, B. Effects of silver nanoparticles on Staphylococcus aureus contaminated open wounds healing in mice: An experimental study. Vet. Res. Forum 2017, 8, 23–28. [Google Scholar]
- Dai, X.; Guo, Q.; Zhao, Y.; Zhang, P.; Zhang, T.; Zhang, X.; Li, C. Functional silver nanoparticle as a benign antimicrobial agent that eradicates antibiotic-resistant bacteria and promotes wound healing. ACS Appl. Mater. Inter. 2016, 8, 25798–25807. [Google Scholar] [CrossRef]
- Gordienko, M.G.; Palchikova, V.V.; Kalenov, S.V.; Lebedev, E.A.; Belov, A.A.; Menshutina, N.V. The Alginate–Chitosan Composite Sponges with Biogenic Ag Nanoparticles Produced by Combining of Cryostructuration, Ionotropic Gelation and Ion Replacement Methods. Int. J. Polym. Mater. Polym. Biomater. 2022, 71, 34–44. [Google Scholar] [CrossRef]
- Wu, Z.; Zhou, W.; Deng, W.; Xu, C.; Cai, Y.; Wang, X. Antibacterial and Hemostatic Thiol-Modified Chitosan-Immobilized AgNPs Composite Sponges. ACS Appl. Mater. Interfaces 2020, 12, 20307–20320. [Google Scholar] [CrossRef]
- Motelica, L.; Ficai, D.; Ficai, A.; Truşcă, R.D.; Ilie, C.I.; Oprea, O.C.; Andronescu, E. Innovative Antimicrobial Chitosan/Zno/Ag Nps/Citronella Essential Oil Nanocomposite—Potential Coating for Grapes. Foods 2020, 9, 1801. [Google Scholar] [CrossRef] [PubMed]
- Lan, G.; Li, Q.; Lu, F.; Yu, K.; Lu, B.; Bao, R.; Dai, F. Improvement of platelet aggregation and rapid induction of hemostasis in chitosan dressing using silver nanoparticles. Cellulose 2019, 27, 385–400. [Google Scholar] [CrossRef]
- Mishra, S.K.; Raveendran, S.; Ferreira, J.M.F.; Kannan, S. In Situ Impregnation of Silver Nanoclusters in Microporous Chitosan-PEG Membranes as an Antibacterial and Drug Delivery Percutaneous Device. Langmuir 2016, 32, 10305–10316. [Google Scholar] [CrossRef]
- International Standard ISO 62, Third edition 2008-02-15; Plastics–Determination of water absorption. ISO copyright office Case postale 56, CH-1211; ISO: Geneva, Switzerland, 2008.
- International Standard, ASTM D570; Standard Test Method for Water Absorption of Plastics, 2022 Edition. ASTM International (ASTM): West Conshohocken, PA, USA, 1 September 2022.
- Rohindra, D.R.; Nand, A.V.; Khurma, J.R. Swelling properties of chitosan hydrogels. South Pac. J. Nat. Appl. Sci. 2004, 22, 32–35. [Google Scholar] [CrossRef]
- Abd El-Hady, M.M.; Saeed, S.E. Antibacterial Properties and pH Sensitive Swelling of Insitu Formed Silver-Curcumin Nanocomposite Based Chitosan Hydrogel. Polymers 2020, 12, 2451. [Google Scholar] [CrossRef] [PubMed]
- CLSI Standard 2022; Clinical & Laboratory Standards Institute: Performance Standards for Antimicrobial Susceptibility Testing, 32rd Edition. CLSI Standard: Wayne, PA, USA, 2022.
- Motelica, L.; Ficai, D.; Oprea, O.-C.; Ficai, A.; Ene, V.-L.; Vasile, B.-S.; Andronescu, E.; Holban, A.-M. Antibacterial Biodegradable Films Based on Alginate with Silver Nanoparticles and Lemongrass Essential Oil–Innovative Packaging for Cheese. Nanomaterials 2021, 11, 2377. [Google Scholar] [CrossRef]
- Spoială, A.; Ilie, C.-I.; Dolete, G.; Croitoru, A.-M.; Surdu, V.-A.; Trușcă, R.-D.; Motelica, L.; Oprea, O.-C.; Ficai, D.; Ficai, A.; et al. Preparation and Characterization of Chitosan/TiO2 Composite Membranes as Adsorbent Materials for Water Purification. Membranes 2022, 12, 804. [Google Scholar] [CrossRef]
- Grande Tovar, C.D.; Castro, J.I.; Valencia Llano, C.H.; Navia Porras, D.P.; Delgado Ospina, J.; Valencia Zapata, M.E.; Herminsul Mina Hernandez, J.; Chaur, M.N. Synthesis, Characterization, and Histological Evaluation of Chitosan-Ruta Graveolens Essential Oil Films. Molecules 2020, 25, 1688. [Google Scholar] [CrossRef]
- Thambiliyagodage, C.; Jayanetti, M.; Mendis, A.; Ekanayake, G.; Liyanaarachchi, H.; Vigneswaran, S. Recent Advances in Chitosan-Based Applications—A Review. Materials 2023, 16, 2073. [Google Scholar] [CrossRef]
- Cotar, A.I.; Grumezescu, A.M.; Andronescu, E.; Voicu, G.; Ficai, A.; Ou, K.-L.; Huang, K.-S.; Chifiriuc, M.C. Nanotechnological solution for improving the antibiotic efficiency against biofilms developed by gram-negative bacterial strains. Lett. Appl. NanoBioSci. 2013, 2, 97–104. [Google Scholar]

| Sample | Mass Loss RT-150 °C | Mass Loss 150–255 °C | Mass Loss 255–620 °C | Endo I | Exo I |
|---|---|---|---|---|---|
| P01 | 5.61% | 43.26% | 47.98% | 90.0 °C | 225.5 °C |
| P3L | 6.41% | 33.22% | 58.36% | 102.1 °C | 233.3 °C |
| P02 | 9.21% | 50.07% | 38.56% | 106.5 °C | 228.7 °C |
| P6L | 7.01% | 29.13% | 61.55% | 88.9 °C | 227.8 °C |
| Lavender Essential Oil | |
|---|---|
| Bacterial Strains | Minimal Inhibitory Concentration (%) |
| E. faecalis VRE 2566 | 5% |
| S. epidermidis 2018 | 2.5% |
| E. coli ATCC 35218 | 0.625% |
| K. pneumoniae ATCC 10031 | 1.25% |
| Sample Code | Chitosan (g in 100 mL of 3% (v/v) AcA) | Ag NPs (mL of 100 ppm Solution) | LEO (mL) |
|---|---|---|---|
| P01 | 2 g | - | - |
| P1L | 2 g | - | 1 |
| P2L | 2 g | - | 2 |
| P3L | 2 g | - | 5 |
| P02 | 2 g | 2 | - |
| P4L | 2 g | 2 | 1 |
| P5L | 2 g | 2 | 2 |
| P6L | 2 g | 2 | 5 |
Disclaimer/Publisher’s Note: The statements, opinions and data contained in all publications are solely those of the individual author(s) and contributor(s) and not of MDPI and/or the editor(s). MDPI and/or the editor(s) disclaim responsibility for any injury to people or property resulting from any ideas, methods, instructions or products referred to in the content. |
© 2023 by the authors. Licensee MDPI, Basel, Switzerland. This article is an open access article distributed under the terms and conditions of the Creative Commons Attribution (CC BY) license (https://creativecommons.org/licenses/by/4.0/).
Share and Cite
Gheorghiță, D.; Antoniac, I.; Moldovan, H.; Antoniac, A.; Grosu, E.; Motelica, L.; Ficai, A.; Oprea, O.; Vasile, E.; Dițu, L.M.; et al. Influence of Lavender Essential Oil on the Physical and Antibacterial Properties of Chitosan Sponge for Hemostatic Applications. Int. J. Mol. Sci. 2023, 24, 16312. https://doi.org/10.3390/ijms242216312
Gheorghiță D, Antoniac I, Moldovan H, Antoniac A, Grosu E, Motelica L, Ficai A, Oprea O, Vasile E, Dițu LM, et al. Influence of Lavender Essential Oil on the Physical and Antibacterial Properties of Chitosan Sponge for Hemostatic Applications. International Journal of Molecular Sciences. 2023; 24(22):16312. https://doi.org/10.3390/ijms242216312
Chicago/Turabian StyleGheorghiță, Daniela, Iulian Antoniac, Horațiu Moldovan, Aurora Antoniac, Elena Grosu, Ludmila Motelica, Anton Ficai, Ovidiu Oprea, Eugeniu Vasile, Lia Mara Dițu, and et al. 2023. "Influence of Lavender Essential Oil on the Physical and Antibacterial Properties of Chitosan Sponge for Hemostatic Applications" International Journal of Molecular Sciences 24, no. 22: 16312. https://doi.org/10.3390/ijms242216312
APA StyleGheorghiță, D., Antoniac, I., Moldovan, H., Antoniac, A., Grosu, E., Motelica, L., Ficai, A., Oprea, O., Vasile, E., Dițu, L. M., & Raiciu, A. D. (2023). Influence of Lavender Essential Oil on the Physical and Antibacterial Properties of Chitosan Sponge for Hemostatic Applications. International Journal of Molecular Sciences, 24(22), 16312. https://doi.org/10.3390/ijms242216312

